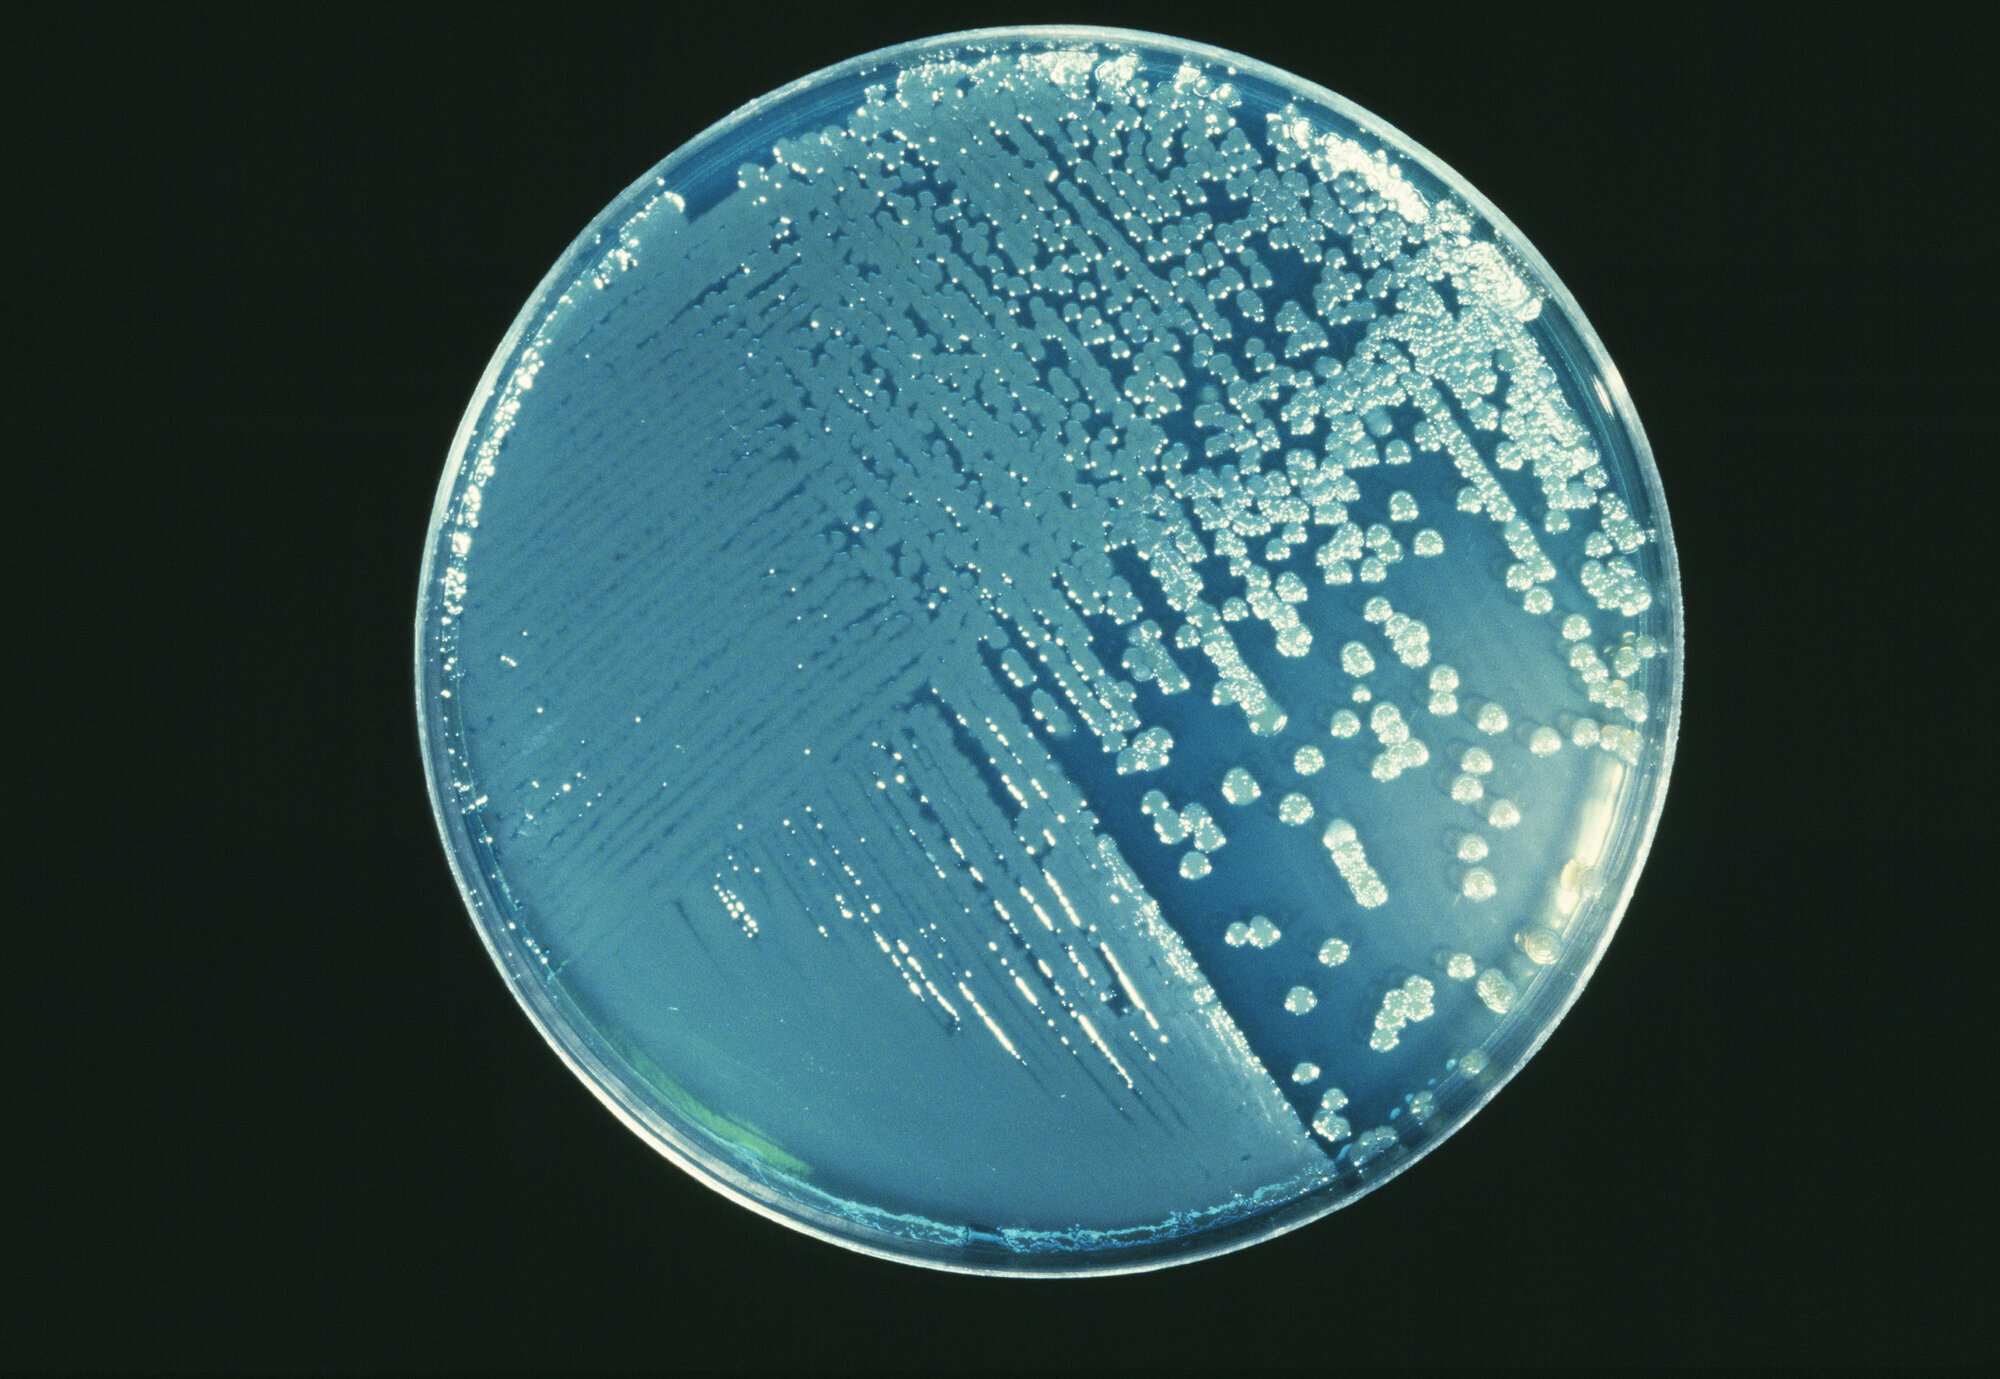
Pseudomonas aeruginosa, petriskål Bildet viser en petriskål med Pseudomonas aeruginosa.

Bakterieutbruddet: Produsent tilbakekaller flere produkter
Det er produkter av merkene Oasis og Conti som nå trekkes tilbake.
Etter funn av Pseudomonas aeruginosa i vaskekluter av typen Oasis Bedbath, har det norske Mattilsynet frarådet bruk av alle Oasis-produkter.
Nå har produsenten selv, Vernacare, tatt initiativ til å kalle tilbake Oasis-produkter, og også produkter av merket Conti. Begge produseres på samme fabrikk i England.
Det er Mattilsynet som opplyser dette i en pressemelding.
I alt 13 produkter
Leverandører av produktene i EU og EØS har mottatt en liste over hvilke som tilbakekalles. Det er totalt 13 produkter.
Mattilsynet følger opp distribusjonen, og de ansvarlige importørene stopper salget.
Flere av produktene omsettes ikke i Norge. Men det kan være at noen produkter omsettes på andre nettsider, og derfor velger Mattilsynet å informere om alle produktene.
Produktene som tilbakekalles er:
- Oasis Bedbath – Perfumed
- Oasis Bedbath – Unperfumed
- Oasis Maceratable Bedbath – Perfumed
- Oasis Maceratable Bedbath – Unperfumed
- Oasis Shampoo Cap – Unperfumed
- Oasis Shampoo Cap – Perfumed
- Oasis Washmitt – Unperfumed
- Oasis Washmitt – Perfumed
- Conti Flushable Skin Cleansing Wet Wipes
- Conti Continence CARE Skin Cleansing Wipes
- Conti Patient Cleansing Wet Wipes
- Conti Skin Cleansing Wet Wipes
- Conti Continence CARE 3 % Dimethicone Barrier Cloth
Skal returneres
De tilbakekalte produktene skal ikke brukes, og de skal returneres til ansvarlig virksomhet.
Mattilsynet skriver at man skal ta kontakt med leverandør for mer informasjon om hvordan produktene skal returneres.
Tilbakekallingen gjelder uavhengig av produksjonsdato og holdbarhetsdato.
314 pasienter på 37 sykehus
Det var i november klinikere på Universitetssykehuset i Nord-Norge reagerte på at tre pasienter fikk blodbaneinfeksjon og døde. Alle tre viste seg å være smittet med Pseudomonas aeruginosa, og en helgenomsekvensering viste at bakteriestammen var den samme.
Det ble slått utbruddsalarm, og en omfattende etterforskning ble satt i gang.
I mars oppdaget smitteverneksperter på Oslo universitetssykehus bakterien i engangs vaskekluter av typen Oasis Bedbath.
Produsenten ble straks informert, og har samarbeidet med norske myndigheter om å oppklare utbruddet.
Pseudomonas aeruginosa gir sjelden sykdom hos friske, men kan gi alvorlig sykdom hos intensivpasienter og mennesker med svekket immunforsvar.
Bakterien skal derfor ikke være til stede i vaskekluter eller tilsvarende produkter.
Så langt omfatter utbruddet 314 pasienter på 37 norske sykehus.





















0 Kommentarer